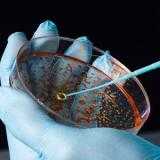
Thumbnail

Diversey Knowledge-Based Services
Today, and increasingly in the future, food and beverage processors must measure key performance indicators (KPIs) to be competitive, to run operations efficiently, to meet changing environmental demand, exceed food safety standards, and be responsible brand stewards. But with so much data available how can you capture and use this KPI data to improve efficiency, food safety and drive profitability? The challenge to food and beverage manufacturers is how to produce quality and safe products whilst reducing operational costs, in order to stay competitive. That is why we have introduced our Knowledge Based Services - a suite of services to help you achieve your goals.

Operating Efficiency and Food Safety Improvement Projects for Food and Beverage Facilities
The Diversey Knowledge-Based Services portfolio addresses key food and beverage industry challenges: Productivity, Water, Energy, Yield and Food Safety. The services share a common three-step 'Check, Analysis and Solve' approach to continually improve food safety and operational efficiency in food and beverage processing plants.
Download the Knowledge-Based Services PDF Catalog.
The Services